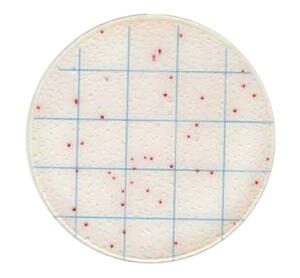
Gvs GVS MicroPad product image 2
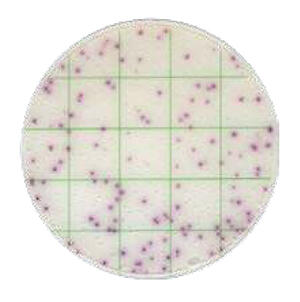
Gvs GVS MicroPad product image 3

Gvs GVS MicroPad, Mikrobiológiai elemző
Termék tulajdonságai
- Alkalmazási terület: Italipar, üdítőital-gyártás, ásványvíz, söripar, élelmiszeripar, vízvizsgálat, HACCP, környezeti monitoring
- Detektálás: Színkódolt kolóniák, vizuális számlálás
- Felhasználás módja: Közvetlen mintapipettázás, agar és reagensek nélkül
- Inkubálási idő: 18 - 48 óra (típustól függően)
- Kimutatható mikroorganizmusok: Összcsíraszám (TVC), E. coli, coliform, élesztő, penész, Listeria, Salmonella, Staphylococcus aureus, tejsavbaktériumok
- Kompatibilitás: ISO, AOAC
- Módszer: Készre adagolt mikrobiológiai tenyésztőlemez (Petrifilm alternatíva)
- Vizsgálati módszer: Mikrobiológiai csíraszám meghatározás
Termék leírása
GVS MicroPad gyors mikrobiológiai lemezek ital- és élelmiszeripari QC-hez
A GVS MicroPad egy készre adagolt mikrobiológiai tenyésztőlemez rendszer, amely gyors és megbízható megoldást kínál italipari, élelmiszeripari és vízvizsgálati mikrobiológiai ellenőrzéshez. A MicroPad lemezek ISO és AOAC kompatibilisek, és ideálisak üdítőital-, ásványvíz-, sör- és palackozóüzemi minőségellenőrzéshez,... Tovább
A GVS MicroPad egy készre adagolt mikrobiológiai tenyésztőlemez rendszer, amely gyors és megbízható megoldást kínál italipari, élelmiszeripari és vízvizsgálati mikrobiológiai ellenőrzéshez. A MicroPad lemezek ISO és AOAC kompatibilisek, és ideálisak üdítőital-, ásványvíz-, sör- és palackozóüzemi minőségellenőrzéshez,... Tovább
Termék weboldala
Utolsó frissítés dátuma:
2026-03-10 03:58 *
A termék forgalmazója
100%
válaszarány
2 nap
válaszidő
-
Válaszarány:
A beérkezett ajánlatkérések hány százalékára válaszolt a cég.
Válaszidő:
Ez a szám azt mutatja, hogy átlagosan mennyi idő alatt válaszoltál az ajánlatkérésekre. Az átlagba csak a megválaszolt ajánlatkérések számítanak bele.
(A statisztikák az elmúlt 180 nap adatai alapján készülnek.)
Értékelés:
A cég kiadott ajánlatait, az ajánlatkérők így értékelték.
zöld jelzőlámpás cég ⭐

Ez a cég a bisnode által zöld minősítést kapott.
Árbevétel
103 610 000 (Ft)
Adózott eredmény
-871 000 (Ft)
Jegyzett tőke
3 000 000 (Ft)
Adószám
24887597-2-42
Alapítás
2014
Cég státusza
Működő
Negatív esemény
Nincs